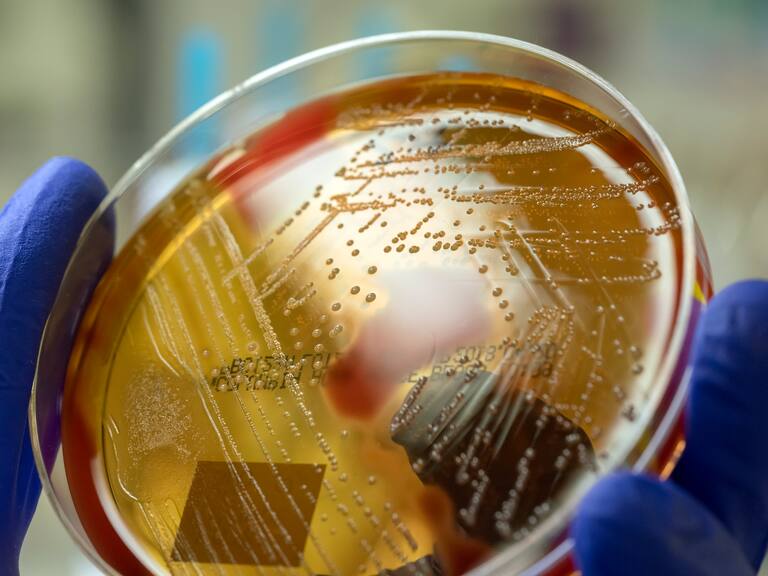
Getty Images

Alerta por “bacteria asesina” en Chile: infectólogo explica qué es, cómo identificarla y cuáles son sus síntomas
En conversación con Ciudadano ADN, el médico Reinaldo Rosas, de la Clínica Alemana, detalló los riesgos y prevención de esta peligrosa infección.
Getty Images / Rodolfo Parulan Jr.
La reciente alerta sanitaria en Chile ha puesto en el foco a la denominada “bacteria asesina”, Streptococcus pyogenes. Esta bacteria ha causado preocupación debido a su asociación con casos graves de influenza.
Para aclarar la situación, el médico Reinaldo Rosas, infectólogo de la Clínica Alemana, conversó con Ciudadano ADN sobre los riesgos, síntomas y prevención de esta peligrosa infección.
Revisa también

“Esta bacteria es conocida por causar infecciones comunes como amigdalitis e infecciones en la piel. Sin embargo, en el último año hemos observado un aumento en infecciones invasoras que son mucho más severas”, indicó el especialista. En concreto, estas infecciones se producen cuando la bacteria logra pasar al torrente sanguíneo y puede afectar órganos internos, haciendo que enfermedades comunes se conviertan en cuadros graves.
Bacteria más influenza
Una de las principales preocupaciones es la combinación de esta bacteria con la influenza. “La influenza puede abrir la puerta a esta bacteria que normalmente reside en la garganta, permitiéndole pasar a la sangre y causar infecciones severas en los pulmones”, explicó Rosas. Este fenómeno es particularmente alarmante durante la temporada de influenza, que ya ha elevado las alertas del Ministerio de Salud.
Ante esto, el infectólogo enfatizó la importancia de reconocer los síntomas de gravedad para buscar atención médica oportuna. “Cuadros prolongados de fiebre, dificultad respiratoria y síntomas de postración, especialmente en niños y adultos mayores, son señales claras de que se debe consultar a un médico”, señaló. Subrayó que, aunque no se debe saturar los servicios de urgencia por síntomas leves, es crucial estar atentos a cualquier evolución inusual de enfermedades respiratorias.
Además de la importancia de la detección temprana, Rosas hizo un llamado a la vacunación. “Las personas que no se han vacunado contra la influenza aún están a tiempo de hacerlo. La vacunación es una medida eficaz para reducir el riesgo de complicaciones graves asociadas a la influenza y, por ende, a las infecciones por Streptococcus pyogenes”, aseguró.
El infectólogo también abordó la percepción alarmista que pueden generar términos como “bacteria asesina”. “Aunque estas infecciones severas tienen una alta letalidad, es importante saber que pueden manejarse y tratarse adecuadamente si se detectan a tiempo”, afirmó el médico, quien además destacó que los casos letales suelen ser aquellos donde el diagnóstico fue tardío o donde hubo una respuesta inadecuada al tratamiento inicial.
En conclusión, la combinación de la influenza con la bacteria Streptococcus pyogenes representa un riesgo significativo, pero con medidas de prevención adecuadas y una vigilancia estrecha, es posible mitigar este riesgo. El médico Rosas reiteró la importancia de la vacunación y la vigilancia de síntomas graves, concluyendo que “la educación y la prevención son nuestras mejores herramientas para enfrentar esta amenaza”.
Sigue a ADN.cl en Google Discover
Recibe nuestros contenidos directamente en tu feed.























